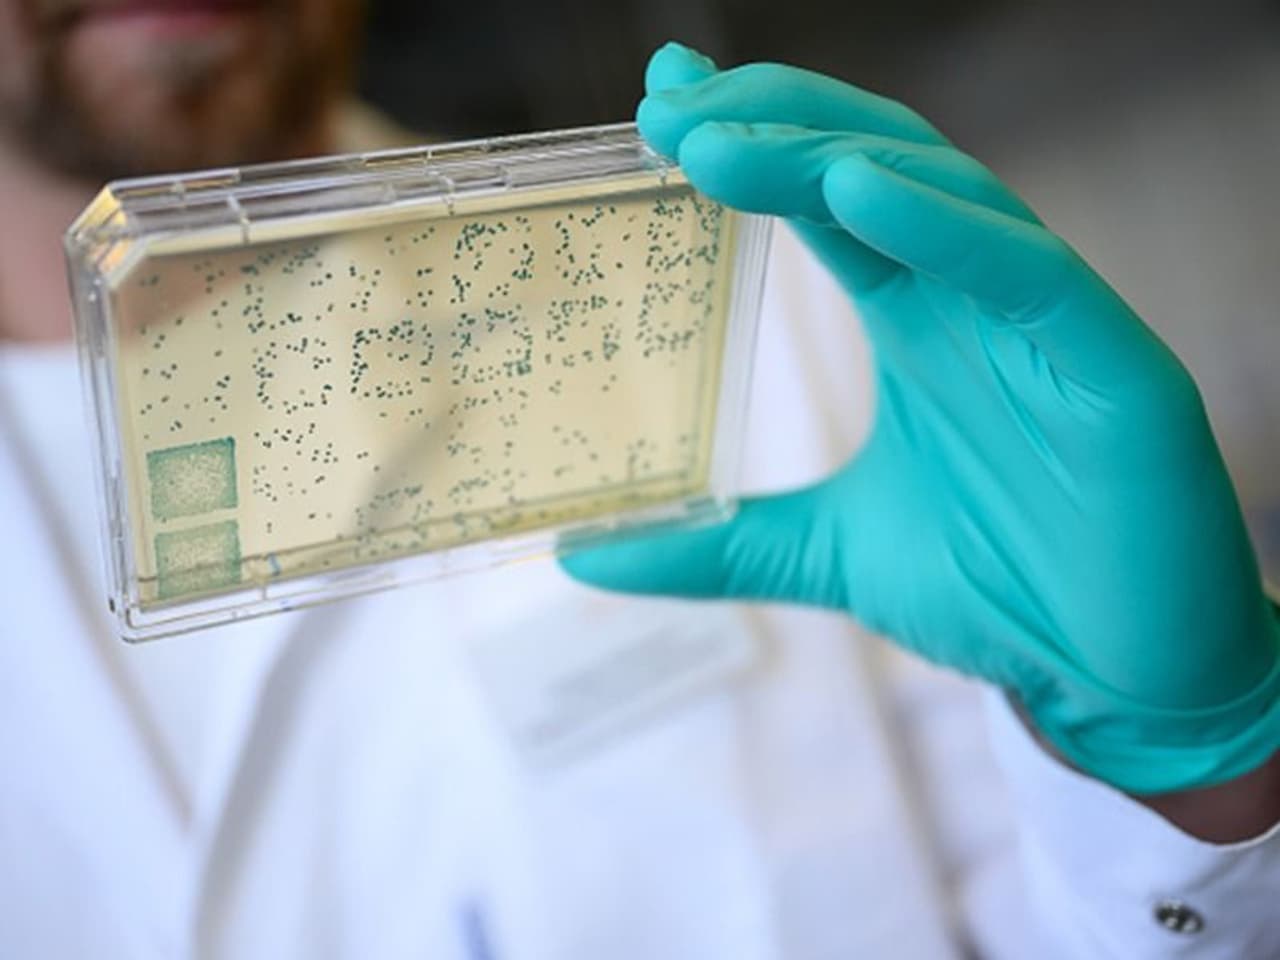

- Home
- West Bengal
- কোভিড সংক্রমণ উর্ধ্বমুখী রাজ্যের এই জেলাগুলিতে, ধীরগতিতে বাড়ছে সুস্থতার হার, দেখুন ছবি
কোভিড সংক্রমণ উর্ধ্বমুখী রাজ্যের এই জেলাগুলিতে, ধীরগতিতে বাড়ছে সুস্থতার হার, দেখুন ছবি
কোভিড গ্রাফ ফের উর্ধ্বমুখী কলকাতা সহ রাজ্যে। চিন্তা বাড়াচ্ছে এই ৩ জেলা। উত্তর ২৪ পরগণা, পশ্চিম মেদিনীপুর এবং দার্জিলিং। রাজ্যে সুস্থতার হারও দ্রত বৃদ্ধি পাচ্ছে না। এখনও আটকে ৯৭ এর ঘরেই। রবিবারের স্বাস্থ্য ভবনের বুলেটিন অনুযায়ী রাজ্যে এই মুহূর্তে একদিনে আক্রান্ত হয়েছেন, ১ হাজার ২৯৭ জন এবং মৃত্যু হয়েছে ২০ জনের। চলুন দেখে নেওয়া যাক বাংলা তথা কলকাতার কোভিড পরিস্থিতি ছবিতে-ছবিতে।
রবিবারের স্বাস্থ্য ভবনের করোনা বুলেটিন অনুযায়ী, পশ্চিমবঙ্গে একদিনে করোনা নিয়ে মৃত্যুর সংখ্যা ২০ জন এবং এর মধ্যে কলকাতায় একদিনে মৃত্যু সংখ্যা ৩ জন। কলকাতায় মোট মৃতের সংখ্যা ৪,৯৩২ । উত্তর ২৪ পরগণায় মৃত্যু হয়েছে ৬ জনের।
রবিবারের স্বাস্থ্য ভবনের করোনা বুলেটিন অনুযায়ী, একদিনে কলকাতায় করোনার নতুন ঢেউয়ে আক্রান্তের সংখ্যা ১১১ জন এবং কলকাতায় মোট আক্রান্তের সংখ্যা ৩০৮,৫৯৪ জন। রাজ্যে এই মুহূর্তে মোট আক্রান্ত ১৫,০৫,৩৯৪ জন।
করোনার নতুন ঢেউয়ে উত্তর ২৪ পরগণায় একদিনে আক্রান্ত ১৭২ জন। তবে সংক্রমণে সব জেলাকেও পিছনে ফেলে করোনায় প্রথম স্থানে উত্তর ২৪ পরগণা। দ্বিতীয় পশ্চিম মেদিনীপুর । পশ্চিম মেদিনীপুরেও একদিনে আক্রান্ত ১৫৬ জন।
চিন্তা বাড়াচ্ছে দার্জিলিং। উত্তর ২৪ পরগণার প্রায় সমানে সমানে কলকাতাতেও টপকে দাড়িয়ে দার্জিলিং জেলা। করোনার নতুন ঢেউয়ে দার্জিলিং একদিনে করোনা আক্রান্ত ১২২ জন। কোভিডে একদিনের আক্রান্তে তৃতীয় স্থানে দার্জিলিং।
রবিবারের স্বাস্থ্য ভবনের করোনা বুলেটিন অনুযায়ী, একদিনে বাংলায় করোনা আক্রান্ত ১ হাজার ২৯৭ জন। পশ্চিমবঙ্গে এই অবধি মোট অ্য়াক্টিভ আক্রান্তের সংখ্য়া কমে ১৯,৭৮০ জন।
রবিবারের স্বাস্থ্য ভবনের করোনা বুলেটিন অনুযায়ী, পশ্চিমবঙ্গে একদিনে হাসপাতাল থেকে সুস্থ হয়ে বাড়ি ফিরেছেন ১,৭৭৭ জন।
বাংলায় কোভিডজয়ীর সংখ্যা বেড়ে দাঁড়াল ১৪, ৬৮,৮১৫ জন। সুস্থতার হার ৯৭.৬৪ শতাংশে পৌছে গিয়েও ফের কমে যায়। তবে এই মুহূর্তে তেমন বাড়ছে না এই হার। একদিনে ৯৭.৫৭ শতাংশ।
West Bengal News (পশ্চিমবঙ্গের খবর): Read In depth coverage of West Bengal News Today in Bengali including West Bengal Political, Education, Crime, Weather and Common man issues news at Asianet News Bangla.